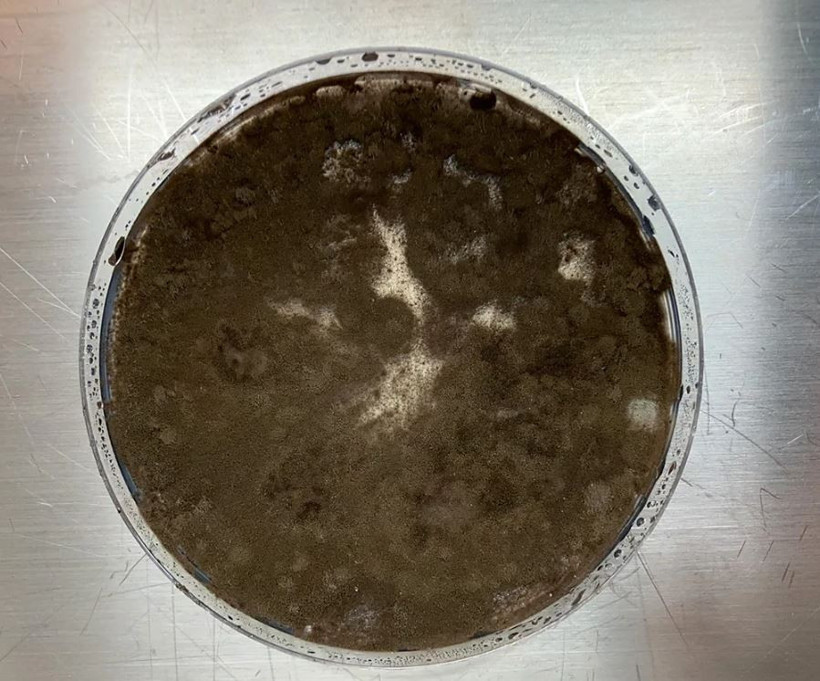
Çernobil'de hayat bulan gizemli mantar: Radyasyon 'yiyor' - Resim : 1

Ukrayna'nın Pripyat kentindeki Çernobil Nükleer Santrali'nde 26 Nisan 1986'da meydana gelen patlama, insanlık tarihinin en büyük nükleer felaketlerinden biri. Patlamadan sonra insanların girişinin yasaklandığı bölgedeki radyasyon seviyeleri, aradan onlarca yıl geçmesine rağmen hâlâ yüksek seviyede.
Ancak bu ölümcül bölgede bilim insanlarını şaşırtan bir canlı bulundu: Cladosporium sphaerospermum adlı siyah bir mantar türü.
Dördüncü reaktörün duvarlarında fark edilen bu mantarın radyasyonun yüksek olduğu yerlerde daha hızlı büyümesi dikkat çekti.
RADYASYONLA BESLENİYOR
Araştırmalara göre mantar, melanin pigmenti sayesinde tıpkı bitkilerin güneş ışığını kullanması gibi, iyonize radyasyonu emip kimyasal enerjiye dönüştürebiliyor. Bu süreç, bitkilerdeki fotosenteze benzer şekilde işliyor ve "radyosentez" olarak adlandırılıyor.
Geçmişte yayınlanan bazı bilimsel makaleler, yüksek radyasyona maruz bırakılan melanin zengini mantarların daha hızlı büyüdüğünü gözler önüne sermişti. Bu durumda da C. sphaerospermum mantarı radyasyonu tolere etmekle kalmıyor, aynı zamanda onunla besleniyor.
Bu keşif, özellikle radyasyonun yüksek olduğu bölgelerde temizleme çalışmaları için devrim yaratabilecek bir gelişme olabilir.
Bu tür mantarların ayrıca aşırı tuzlu, sıcaklığın çok düşük olduğu ya da asiditenin yüksek olduğu ortamlarda da büyüyüp gelişebileceği tespit edildi.
UZAY ARAŞTIRMALARINDA DA TEST EDİLDİ
Uzaydaki yoğun radyasyon, uzun Mars görevleri gibi projeler için de büyük bir tehdit oluşturuyor. Bu yüzden mantar, Uluslararası Uzay İstasyonu'nda da test edildi.
İlk analizler mantarın uzaydaki radyasyonu da emebildiğini gösterdi. Bu da gelecekte astronotları radyasyona karşı korumada bu mantarlardan faydalanılabileceği anlamına geliyor.


 Ukrayna'dan nükleer santrale İHA'lı saldırıDünya
Ukrayna'dan nükleer santrale İHA'lı saldırıDünya
